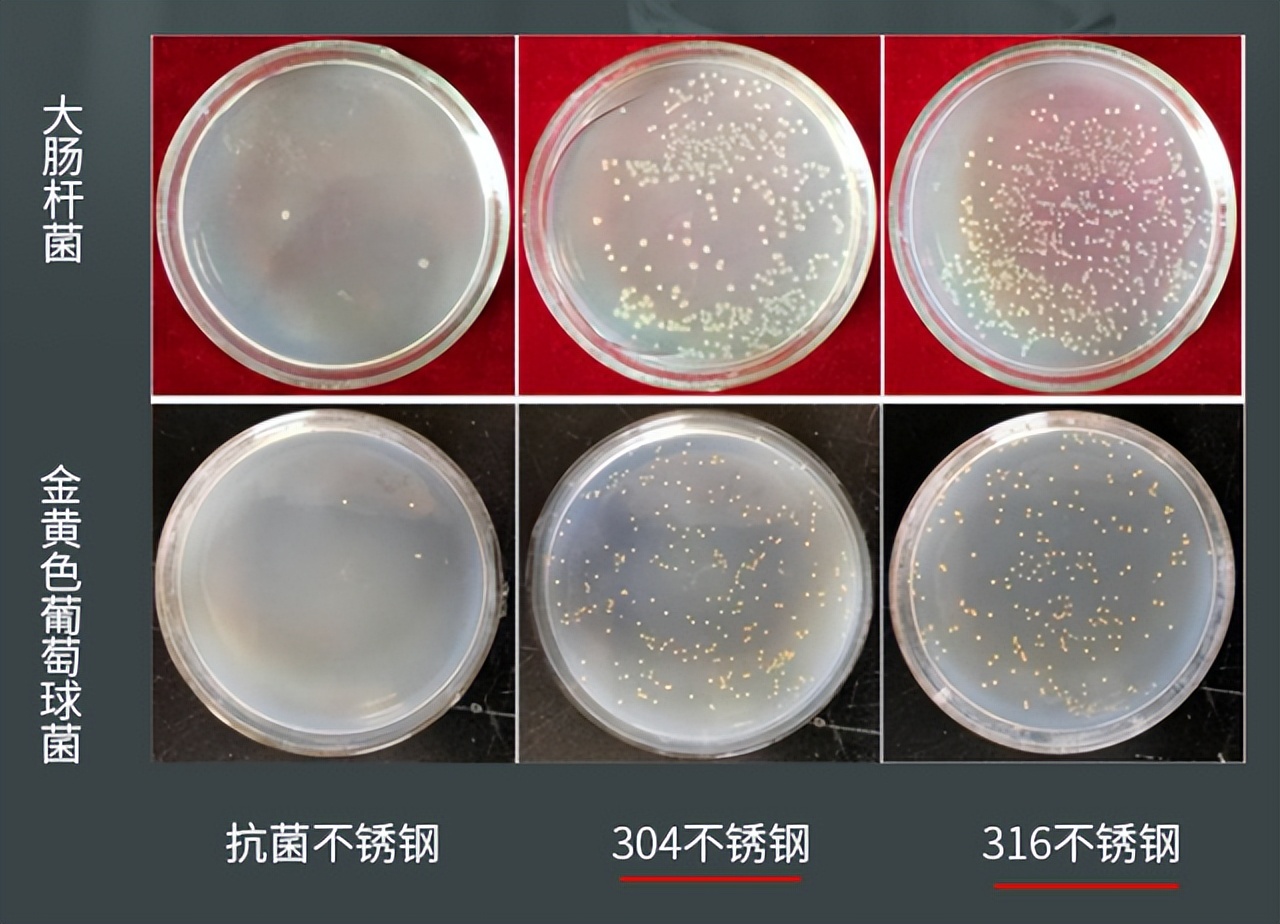

折扣爆料
折扣好货实时更新
日本女人在家务活方面的造诣,在全球都是出了名的,贤惠、勤劳、井井有条,看到日本主妇的房间,强迫症会感觉特别舒服。日本家居收纳做得这么好,除了和日本女人是全职太太有关,跟走心的家居用品设计也有关系。

为什么说他们的家居收纳能如此的得人心呢?有一些厨房小物看似平平无奇,其实设计很巧妙,可以节省我们的时间,提高厨艺。所以建议大家:不管怎样,厨房添置这几样“便宜货”,幸福感立马提升!
1.过滤油壶

厨房做菜的手法有很多,煎炒烹炸,每一种做法都有不同的效果,其中炸是最受家里小孩的欢迎,油炸的食品又香又脆。炸料好吃,但是处理油就很麻烦了,家里炸过一边的油还很干净,直接扔掉太可惜了,原来的油壶又倒不进去了,很多主妇家里随便找一个碗装起来,不仅容易落灰,用着也不方便。

建议大家用上304不锈钢过滤油壶,过滤油壶大开口,带有过滤网,可以很好的过滤油渣,油品干净了,炒菜更香。大容量带盖的设计,不仅装得多,而且可以阻隔灰尘,干净卫生,用着也方便。
2.地板清洁片
厨房的油烟水渍等各个问题,让厨房的地面不忍直视,一进厨房最先看到的是地板,地板也是最容易脏的地方,所以要保持地板的干净。不妨试试这一款地板清洁片,让拖出来的地面焕然一新。

地板清洁片有很好的清洁能力,能够溶解地板的污渍和油渍,地板干净如新。无论是木地板还是瓷砖,都能擦拭得非常干净,还能起到增亮润色的作用,拖出来的地板有亮度有光泽,让家里的档次也上升了很多,家里清洁的到位,彻底,也会让人待得轻松自在!
3.卡贝厨房挂杆
水槽上面墙面安装了一米挂杆,一次过解决刀、砧板、筷子、抹布、刷子、锅盖等收纳问题,不占用橱柜台面空间,整齐不乱,拿取方便。

4.鱼鳞万能抹布

做完饭后厨房的卫生打扫是一件非常重要的事情,像普通的抹布擦拭得不干净而且还容易藏污纳垢滋生细菌,建议不妨试试这种鱼鳞布,它比传统抹布要好用上10倍以上。

它的能力非常强大,抹布上鱼鳞纵横交错,这样加大了摩擦力,所以在清洁起来会非常强,而且用途非常之广。无论是刷碗、擦镜子、洗碗池、不锈钢瓷砖等都可以清洁干净。

而且它脏了也特别容易清洗,直接放在水龙底下即可冲洗干净,简直是日常厨房抹布的不二之选,而且价格还不贵吸水性强,建议大家不妨试试。
5.不锈钢菜板
很多家庭用的菜板都是木质菜板,但是其实木质菜板很容易出现裂痕,而且还会发霉发黑,别提有多少细菌了,但是很多家庭一用就是很多年,根本不舍得换。

其实这样是不对的,发霉发黑的菜板会滋生黄曲霉素,这是严重的致癌物,可能诱发肝癌。因此关于菜板的健康问题,每个家庭都要重视。现在科技发达,科研人员也对菜板做出了新的研究和突破。

不仅实用而且颜值高,质量远超市面上大多数菜板。

专注于不锈钢餐具的CHUZONGGUAN公司,通过多年的研究突破,做出这款抗菌不锈钢双面菜板,更加卫生健康!

有304食品级和316医用级两种可选择,采用拉丝防腐层、高温防蚀层、酸碱防锈层、高温除油层、316/304抛光不锈钢层五层加厚设计,美观更耐用!
不发霉发黑,重量近4斤,分量重不会打滑!
304和316的区别:
316是医用级不锈钢材质,能够有效去除腥味,避免切不同食物时会串味的问题,更不会氧化。
双面使用,生熟分切
不锈钢面可以切菜、肉、海鲜,并且会适当去腥除异味。

食品级小麦秸秆面,可以用来切熟食、水果、甜品之类的,这样就能避免食材交叉影响。
就算是剁肉、砍骨头也不用担心在上面留下划痕,砍骨头剁肉就用小麦秸秆面!

菜板四周用TPR橡胶圈包裹,有效防滑减震,不会打扰到邻居。
不同于传统菜板,不锈钢菜板很容易清洗,用水一冲就干净!

不锈钢光滑,还可以用来擀面、做饺子皮等等,也不会粘!



家里用了很久的木质菜板,建议尽快换成这款不锈钢双面菜板吧!
不发黑发霉、易清洗,特别是家中有老人小孩的,他们抵抗力不是很强,因此要尽快换掉会发黑发霉的木质菜板!
健康、放心、安全、环保的菜板,快给家里买一个!